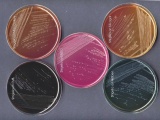

MEDIOS DE CULTIVO
Un medio de cultivo es un conjunto de nutrientes, factores de crecimiento y otros componentes que crean las condiciones necesarias para el desarrollo de los microorganismos.
1. Contener sustancias nutritivas necesarias para el desarrollo de los microorganismos (tales como aminoácidos, carbohidratos, polialcoholes, vitaminas, minerales).
2. Tener un pH que permita un desarrollo óptimo, por lo general las bacterias patógenos necesitan un pH neutro o ligeramente alcalino (7.0 – 7.4), en cambio las levaduras y hongos requieren un pH ácido (5.0).
3. Estar previamente esterilizados o preparados en condiciones asépticas.
4. Estar protegidos de la contaminación ambiental por tapones de algodón cardé, tapones de goma, tapas metálicas o roscas.
1. Aislamiento de bacterias desde una muestra o material patógeno (secreción purulenta, orina, órgano, fecas, etc.) o de un alimento (leche, carne, etc.)
2. Estudio morfológico de las colonias.
3. Conservación de cepas identificadas (colección de cepas microbianas o cepario).
4. Clasificación y tipificación de bacterias por estudio de sus propiedades bioquímicas en medios diferenciales.
5. Obtención de toxinas o investigación de sus características.
6. Cultivo y cosecha de bacterias para la elaboración de productos biológicos (vacunas, antígenos, bacterinas, toxoides, etc.).